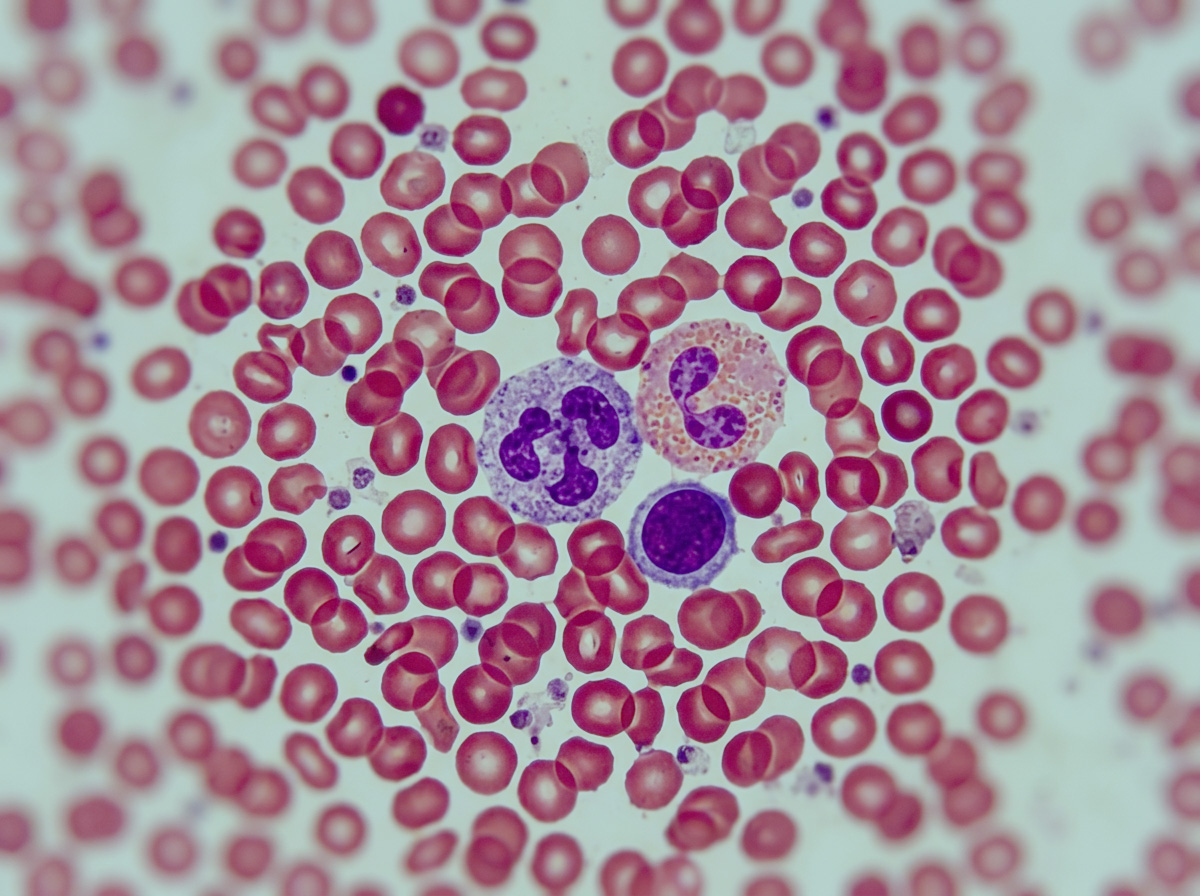

Ветеринария развивается стремительными темпами каждый день. В сферу внедряются новые технологии, которые ранее казались фантастическими. Одно из важнейших направлений, где применяются передовые решения, — изучение строения организмов на микроуровне. Правильно оценить состояние питомца без глубокого понимания мельчайших структур невозможно. Эта статья разложит по полочкам, что такое морфология в ветеринарии, какие методы оценки состояния домашних животных применяются уже сейчас и как инновационное оборудование меняет подход к лечению.
Что такое морфология?
Простыми словами, морфология — это наука о форме и строении организмов. Именно морфология позволяет выявлять нормы и отклонения. Основная роль в медицине — глубинное и комплексное изучение структур организма на разных уровнях.
В ветеринарии морфологию принято делить на три основных ступени:
- Морфология клеток (цитология). Изучение отдельной структурной единицы. Врач оценивает размер, форму, ядро и цитоплазму. Любая измененная клетка может стать первым сигналом проблем в организме любимца.
- Морфология тканей (гистология). Исследование клеточных структур и их взаимодействий. Ткани животных (эпителиальная, мышечная, нервная, соединительная) по-разному реагируют на раздражители и инфекции.
- Морфология органов (анатомия). Изучение сердца, печени, почек и других отдельно взятых органов на микроскопическом уровне.
Морфология в ветеринарии объединяет макро- и микромир. Наука позволяет врачам ставить верные диагнозы и находить наиболее эффективные подходы к лечению.
Преимущества морфологии в ветеринарной практике
Выявление скрытых угроз
Большинство опасных заболеваний у животных проходят без симптомов. Питомец может быть активным, проявлять аппетит, и одновременно болезнь может медленно разрушать внутренние органы. Ранняя диагностика с помощью изучения клеточных структур помогает обнаружить патологии задолго до появления первых клинических симптомов. Скрытые заболевания, такие как хроническая почечная недостаточность или онкология, можно предупредить благодаря микроскопическим исследованиям.
Высокая точность результатов
Морфология важна для диагностики заболеваний, потому что она исключает догадки. Врач видит конкретный возбудитель или изменение. Это обеспечивает высочайшую диагностическую точность. Ошибиться в диагнозе, когда возбудитель виден под микроскопом, практически невозможно.
Внедрение инноваций и AI-инструментов
Сейчас лабораторная диагностика переживает технологическую революцию. Искусственный интеллект в диагностике выходит на первый план. Нейросети обучают распознавать миллионы различных паттернов. AI-анализ сканирует образцы, классифицирует объекты и выдает результат за считанные минуты. Это исключает человеческий фактор и повышает уровень доверия к результатам.
Методы морфологического анализа в ветеринарии
Чтобы получить подробную информацию о здоровье питомца, ветеринары проводят забор биологических материалов. Каждая жидкость или выделение несет свой уникальный массив данных.
Анализ крови
Кровь — главная транспортная система организма. Классическая гематология изучает клетки крови, включая эритроциты, лейкоциты, тромбоциты.
- Что выявляет: воспалительные процессы, анемию, аллергические реакции.
- Специфические маркеры: врач может увидеть незрелые эритроциты (ретикулоциты), это может свидетельствовать о потери крови. Ещё оцениваются гранулоциты (подвид лейкоцитов) для понимания характера иммунного ответа. Кроме того, с помощью мазка крови выявляются кровепаразиты (например, бабезии при укусе клеща).
Ветеринарный врач высшей категории Михаил Шеляков подчёркивает, что биохимический анализ крови — наиболее эффективный инструмент в обнаружении тех заболеваний, которые нельзя определить по внешним признакам.
«Первое, что я всегда советую пациентам, – это сдать биохимический анализ крови. Он определяет диабет, заболевания печени, почек. Что касается гистологии, клеточной морфологии, она более эффективна при исследовании удалённых фрагментов, когда специалист провёл операцию, например».
Анализ мочи
Исследование осадка мочи (микроскопия) — важнейший этап нефрологического обследования.
- Что выявляет: кристаллы солей (песок), цилиндры, эпителий, микроорганизмы (бактерии).
- Значение: помогает диагностировать мочекаменную болезнь, цистит, нефриты и поражения почечных канальцев.
Анализ кала
Копрограмма и исследование на яйца гельминтов.
- Что выявляет: внутренние паразиты (гельминты, простейшие), непереваренные мышечные волокна, жиры, крахмал.
- Значение: оценка работы желудочно-кишечного тракта, печени и поджелудочной железы.
Ручная микроскопия — трудоёмкий процесс, отнимающий много времени. Сегодня специалисты предпочитают автоматизировать исследования. Например, приборы линейки Ozelle — пример внедрения инновационных решений в клиническую практику. Это передовой диагностический инструмент, меняющий правила работы в лаборатории
Роль морфологии в клинической практике
Ежедневно ветеринарный врач сталкивается с десятками сложных случаев. Самые частые симптомы (вялость, отказ от еды, рвота) могут быть признаком сотен различных заболеваний.
Клиническая практика опирается на доказательную базу. Морфология в данном случае становится фундаментом доказательств. Специалисты используют этот подход по следующим причинам:
- Дифференциальная диагностика. Когда симптомы схожи, и лишь детальный анализ показывает истинную причину.
- Мониторинг лечения. Патология может отступать незаметно внешне. Регулярный забор материалов показывает уровень содержания воспалительных агентов.
- Хирургическое планирование. Оценка клеточного состава новообразований перед операцией помогает хирургу выбрать правильную тактику (удалять только опухоль или захватывать прилегающие органы животных).
Как правило, владельцы животных делают неправильные выводы, когда замечают первую симптоматику у питомцев, считает Михаил Шеляков.
«Владельцы делают неправильные выводы, когда видят кровоточащие дёсны у питомцев и полагают, что у них проблемы с почками, например. Это самые частые обращения в нашей практике. Далеко не все хозяева понимают, что дело не в зубах, а в безнадёжном состоянии организма внутри. Это совсем не та проблема. В таких и иных ситуациях всегда отправляю на биохимию», – рассказал нам ветеринар.
Результаты исследования напрямую влияют на клиническое решение. Если в крови обнаружены специфические паразиты, назначается узконаправленный препарат. Если найдено атипичное клеточное строение, животное направляется к онкологу. Без морфологических данных лечение сводилось бы к методу проб и ошибок, и это категорически неправильно.
Зачем нужна морфология для клиники и владельцев животных?
Проще говоря, морфология — реальный инструмент спасения жизней. Глубокий анализ внутренних структур в ветеринарии помогает создавать грамотную стратегию лечения, основанную на неопровержимых фактах в ветеринарии.
Для владельцев питомцев применение таких методов означает уверенность. Раннее выявление проблем бережет здоровье животных, продлевает им жизнь и экономит средства, которые ушли бы на лечение запущенных заболеваний.
Современная ветеринарная клиника, использующая передовое оборудование (подобное системам Ozelle), получает колоссальное конкурентное преимущество. Автоматизация процессов экономит время персонала, исключает человеческий фактор и повышает общий стандарт обслуживания. В конечном итоге, качественная диагностическая база — это залог успешной работы клиники и долголетия четвероногих.